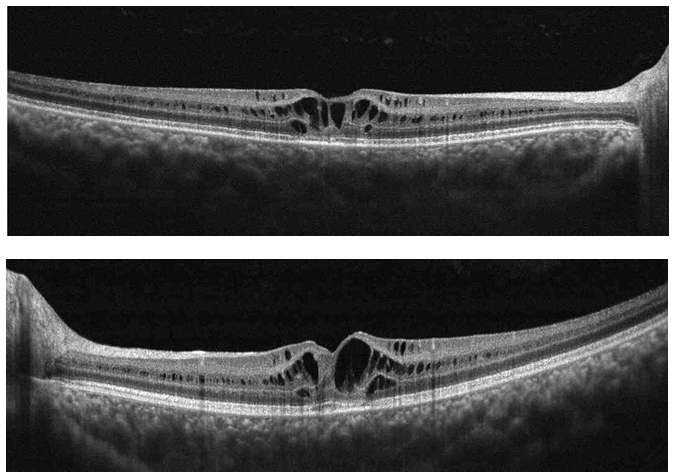

Advances in
eISSN: 2377-4290


Case Report Volume 2 Issue 1
Department of Pediatric Ophthalmology, University of Colorado, USA
Correspondence: Miguel Paciuc Beja, Department of Pediatric Ophthalmology, Denver Health Medical Center, Denver, University of Colorado, USA, Tel 303-436-6558
Received: January 11, 2015 | Published: February 10, 2015
Citation: Beja MP, Cantu DS, Neria PR, et al. Optical coherence tomography in x-linked juvenile retinoschisis. Adv Ophthalmol Vis Syst. 2015;2(1):30-32. DOI: 10.15406/aovs.2015.02.00033
X-linked juvenile retinoschisis clinical presentation varies greatly due to the high phenotypic variability of the affected gene RS1. The use of optical coherence tomography (OCT) has been useful in describing a wide variety of findings in affected patients. In this article we describe the clinical presentation and use of optical coherence tomography in X-linked juvenile retinoschisis.
Keywords: x linked retinoschisis, hereditary retinal dystrophies
OCT: optical coherence tomography; XLRS: x-linked juvenile retinoschisis; RS1: retinoschisis gene
Retinoschisis is the splitting of the neurosensory retina. X-linked juvenile retinoschisis (XLRS) affects male children. It is associated with the retinoschisis gene (RS1), important for encoding an amino acid protein called retinoschisin which binds to the surface of photoreceptors and helps maintain the retina’s integrity. Phenotypic variability is high as well as visual acuity, going from mild to severe visual acuity loss.
The visual acuity in patients with XLRS varies greatly. It is known that in the initial stages of the disease, the central vision is usually normal but when the schisis starts occurring, usually in the first two decades of life, it may decrease to 20/200.1,2 Most young adults present a visual acuity of 20/70. A regular trait found in these patients that has previously been called the hallmark of the disease is the presence of maculopathy. It consists of the finding of foveal schisis which consists of small, cystoid spaces and fine radial striae found in the central macula. Additional findings include peripheral retinoschisis, pigmentary deposits, vitreous hemorrhages, tractional complications, vascular sheathing and a b-wave reduction on the electroretinogram.1−5 In over50% of patients that present with peripheral retinoschisis, it is found in the inferotemporal quadrant.6,7 Figure 1A, 1B & Figure 2A & 2B present the fundus photographes of two brothers with the X linked retinoschisis. Ocular examination revealed stellate maculopathy with foveal retinoschisis bilaterally and sheathing of blood vessels.

Figure 1 (1A) Six year old male. Right Eye and (1B) Left Eye. Foveal radial streaks and sheathing of blood vessels. (1A) Arrow signals macular schisis that gives the impression of a star like pattern. (1B) Arrow signaling vascular attenuation or sheathing.

Figure 2 (2A) Right Eye. Four year old male (2B) Left Eye. Examination revealed bilateral foveal retinoschisis and blood vessel sheathing. (2A) Arrow signaling to the macular stellate spoke like appearance.
OCT
Optical coherence tomography is a non-invasive diagnostic technique that allows morphological and quantitative analysis of living tissue with an axial resolution of nearly 10 microns.8 Studies have demonstrated that OCT imaging show a wide assortment of finding in regards to retinoschisis patients, especially when describing cystoid macular changes.2,9−11 The classic OCT image is described as cavitations compromising the neurosensory retina from its internal to its outer layers with thin septa connecting both layers as previously described by others (Figure 3).1,12−14
Figure 3 (Top) Right Eye and (Bottom) Left Eye Cross Line OCT. Cyst like cavities splitting retina layers.
It has been previously reported that high-speed, high-resolution, Fourier domain OCT can evaluate thinning of the retinal nerve fiber layer in these patients.15 Gerth used high resolution OCT to described retinoschisis findings and reported that the fovea, the full-thickness measurement of inner and outer retina thickness as well as volume measurements were increased in patients with retinoschisis. This measurement increase was attributed to the schisis cavities.16 While using time-domain optical coherence tomography, Apushkin suggested that there was no association between visual acuity and full-thickness foveal thickening or cystic area size (Figure 4).17. Newer studies suggest that visual dysfunction is multifactorial, affected by both inner foveal thickening and temporal perifoveal inner retinal thinning. The schisis associated with inner foveal thickening most likely relates to foveal distortion while inner retinal atrophy related to the inner retina of the temporal perifoveal retina may also play a factor in visual dysfunction.16
OCT is a useful, non invasive tool that helps visualize the vitreoretinal and vitreo macular inter phase. It is helpful in cases of X-linked juvenile retinoschisis due to the fact that it can help relate the images to the clinical presentation, it helps diagnose and allows a comparative status at follow up.
None.
Author declares that there is no conflict of interest.

©2015 Beja, et al. This is an open access article distributed under the terms of the, which permits unrestricted use, distribution, and build upon your work non-commercially.